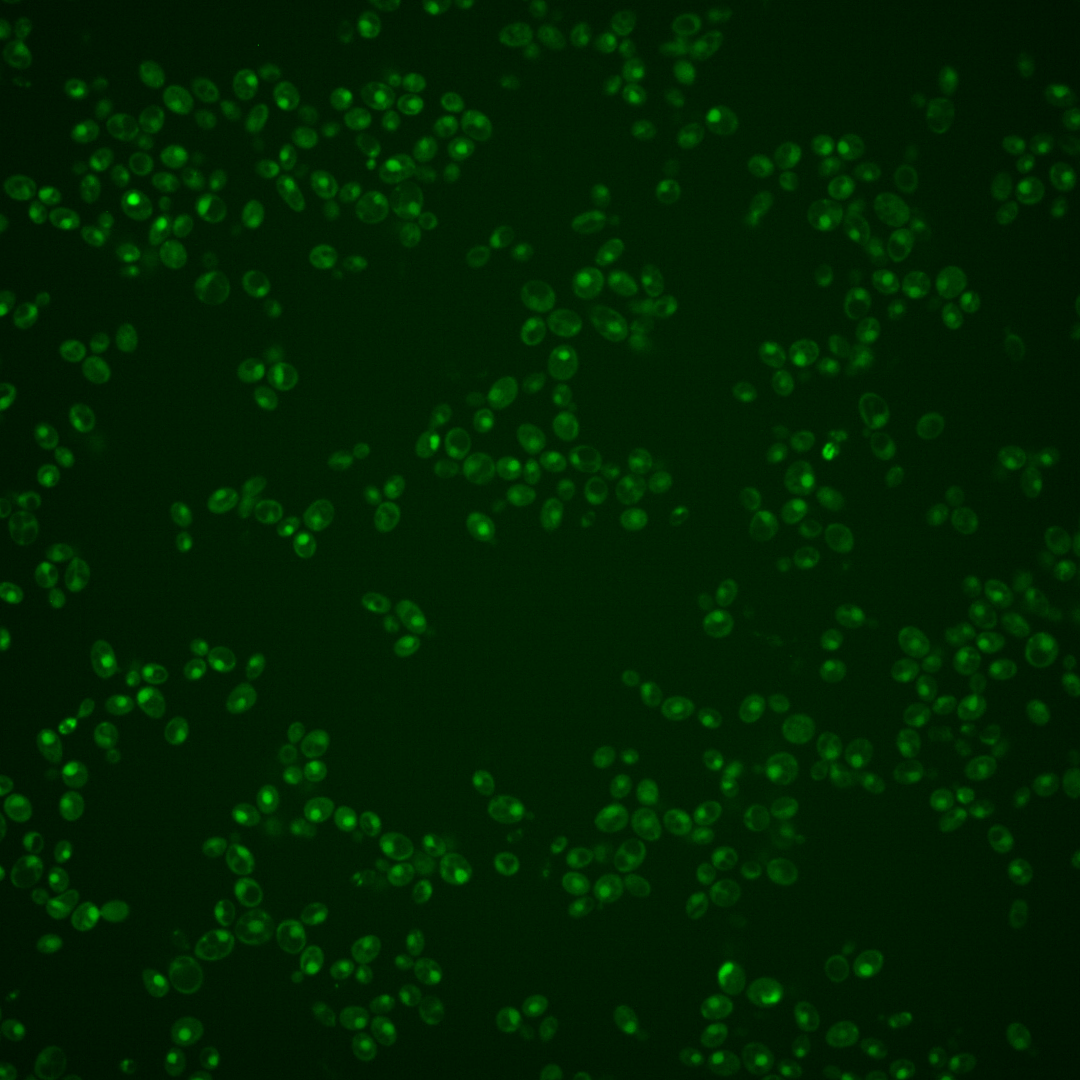
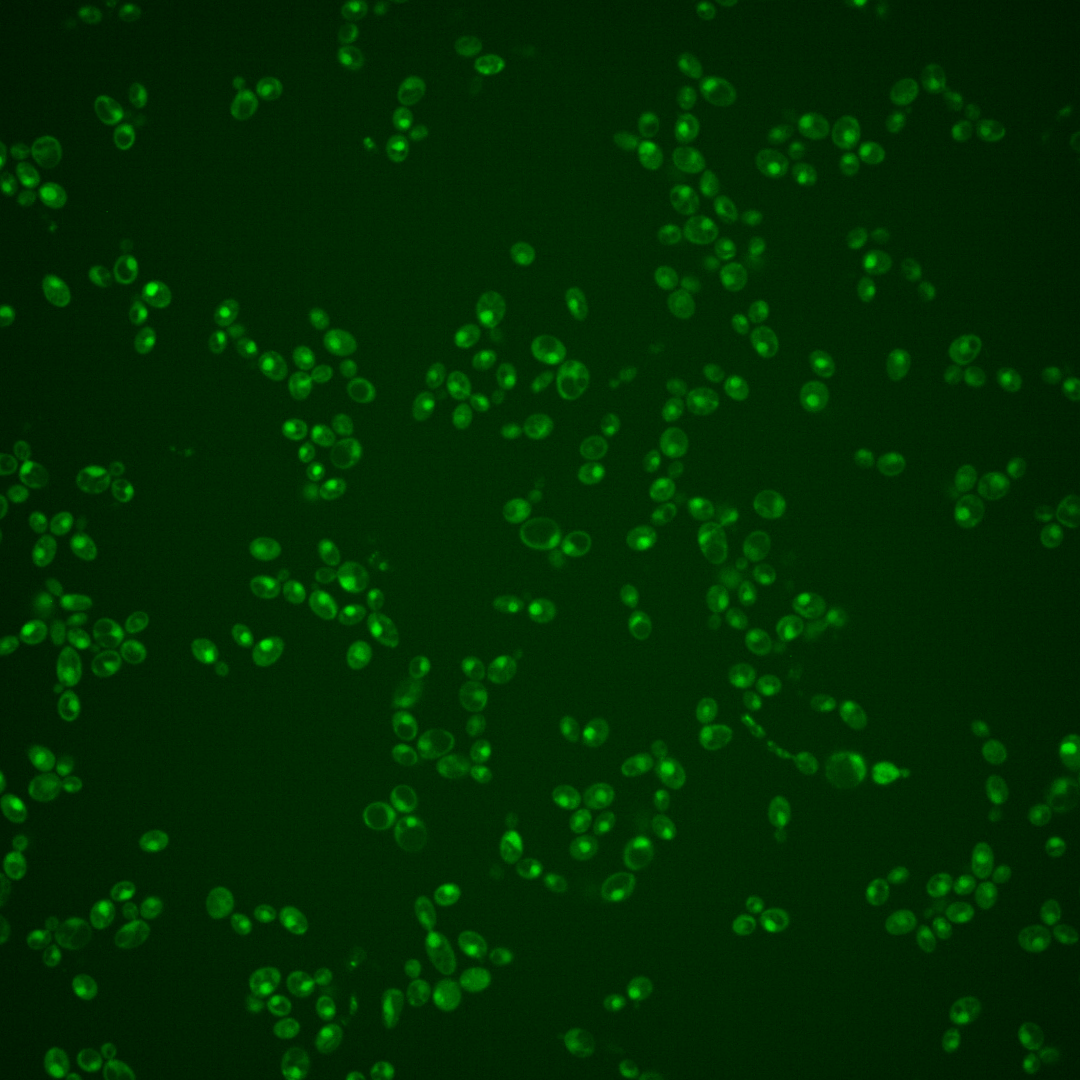
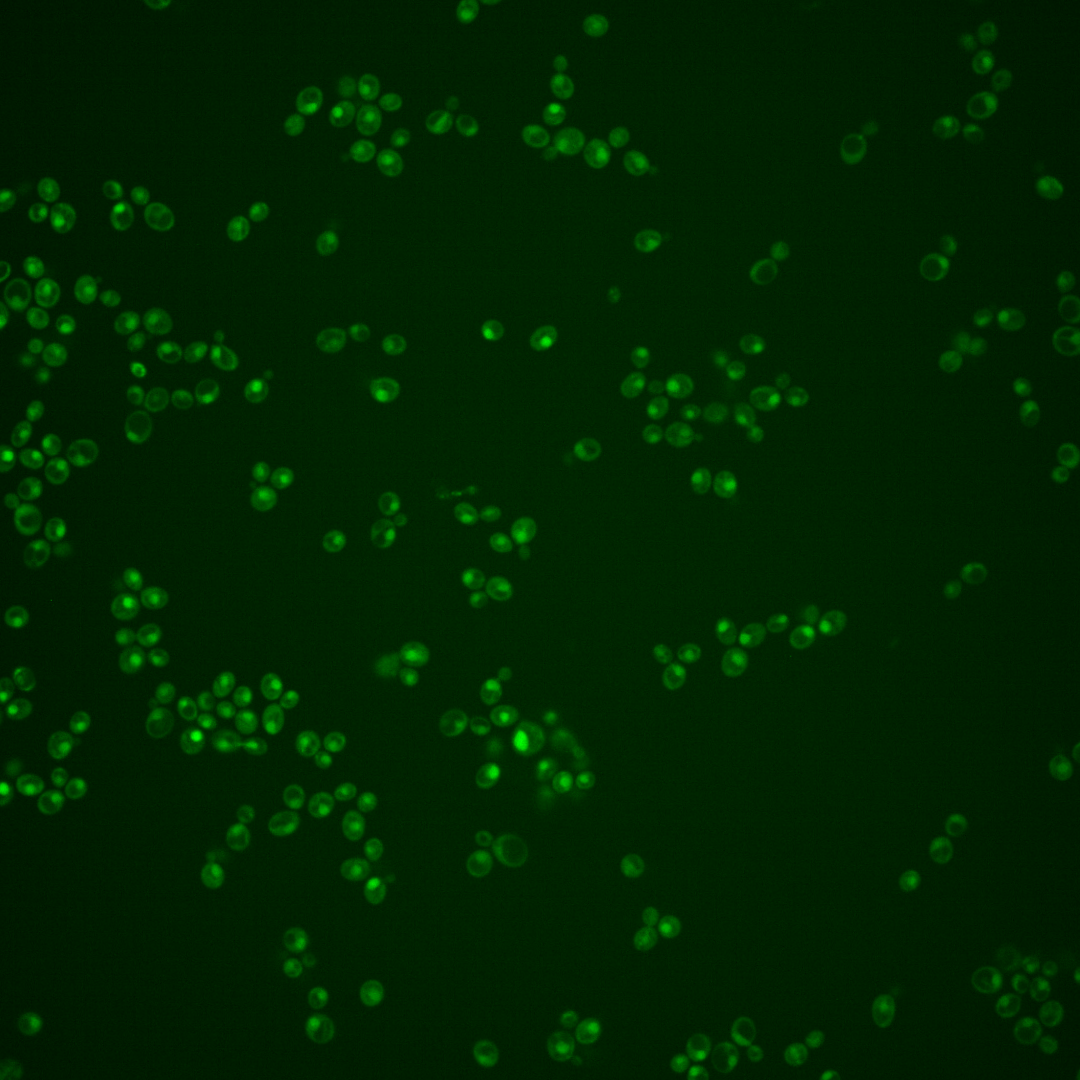
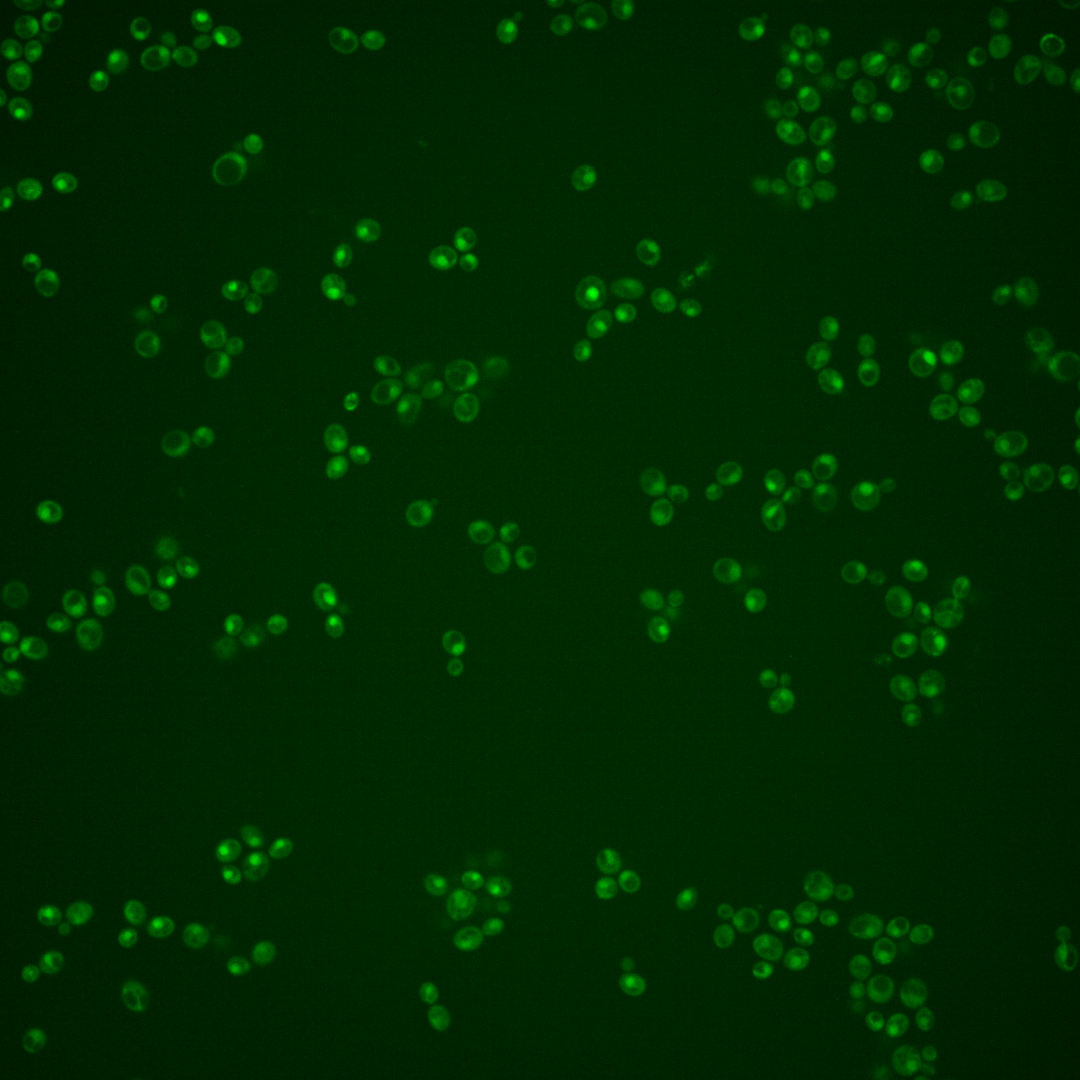

| Standard name | |
|---|---|
| Human Ortholog | |
| Description | Pre-mRNA splicing factor; important for catalytic step II of pre-mRNA splicing and plays a role in cell cycle progression, particularly at the G1/S phase transition; required for DNA synthesis during mitosis and meiosis; has WD repeats; thermosensitivity of the cdc40 null mutant is functionally complemented by a chimeric construct containing the N-terminal 156 amino acids of yeast Cdc40p fused to the C-terminal two thirds (297 amino acids) of human CDC40 |
Micrographs




















































































Sub-cellular Localization
Yeast GFP Assignment
Protein Abundance
Localization Change
External localization resources
| ensLOC | DeepLoc | |||||||||||||||||||||||
|---|---|---|---|---|---|---|---|---|---|---|---|---|---|---|---|---|---|---|---|---|---|---|---|---|
| Localization | WT1 | WT2 | WT3 | RAP60 | RAP140 | RAP220 | RAP300 | RAP380 | RAP460 | RAP540 | RAP620 | RAP700 | HU80 | HU120 | HU160 | rpd3Δ_1 | rpd3Δ_2 | rpd3Δ_3 | WT1 | WT2 | WT3 | AF100 | AF140 | AF180 |
| Cortical Patches | 0 | 0 | 0 | 0 | – | 0 | 0 | 0 | 0 | 0 | 0 | 0 | 0 | 0 | 0 | 0 | 0 | 0 | 0 | 0 | 3 | 0 | 4 | 2 |
| Bud | 0 | 0 | 0 | 0 | – | 0 | 3 | 4 | 10 | 11 | 3 | 14 | 0 | 0 | 0 | 1 | 0 | 0 | 1 | 8 | 4 | 5 | 9 | 8 |
| Bud Neck | 0 | 0 | 0 | 0 | – | 0 | 0 | 1 | 0 | 0 | 0 | 0 | 2 | 0 | 0 | 0 | 0 | 0 | 0 | 2 | 1 | 1 | 4 | 3 |
| Bud Site | 0 | 0 | 0 | 0 | – | 1 | 3 | 5 | 2 | 4 | 8 | 6 | 0 | 0 | 0 | 0 | 0 | 0 | – | – | – | – | – | – |
| Cell Periphery | 0 | 0 | 0 | 0 | – | 0 | 1 | 0 | 0 | 0 | 0 | 0 | 0 | 0 | 0 | 0 | 1 | 0 | 0 | 0 | 0 | 0 | 0 | 0 |
| Cytoplasm | 17 | 51 | 81 | 57 | – | 103 | 122 | 105 | 91 | 85 | 40 | 66 | 96 | 114 | 180 | 104 | 135 | 113 | 12 | 31 | 33 | 69 | 62 | 94 |
| Endoplasmic Reticulum | 1 | 3 | 0 | 0 | – | 0 | 0 | 0 | 0 | 1 | 1 | 0 | 0 | 0 | 2 | 22 | 18 | 14 | 0 | 1 | 6 | 1 | 2 | 3 |
| Endosome | 0 | 5 | 27 | 5 | – | 0 | 1 | 4 | 6 | 0 | 2 | 0 | 18 | 7 | 11 | 40 | 65 | 76 | 3 | 4 | 5 | 5 | 7 | 20 |
| Golgi | 1 | 2 | 0 | 0 | – | 0 | 0 | 0 | 0 | 0 | 0 | 0 | 1 | 0 | 1 | 1 | 2 | 1 | 1 | 2 | 4 | 1 | 2 | 2 |
| Mitochondria | 54 | 21 | 17 | 21 | – | 118 | 190 | 163 | 187 | 252 | 180 | 265 | 2 | 0 | 0 | 30 | 11 | 9 | 6 | 12 | 61 | 14 | 13 | 18 |
| Nucleus | 18 | 44 | 19 | 3 | – | 6 | 23 | 19 | 37 | 32 | 25 | 35 | 47 | 20 | 13 | 30 | 20 | 12 | 32 | 79 | 58 | 118 | 84 | 68 |
| Nuclear Periphery | 0 | 0 | 0 | 0 | – | 0 | 0 | 0 | 1 | 2 | 3 | 5 | 0 | 0 | 0 | 0 | 0 | 0 | 0 | 1 | 4 | 1 | 1 | 1 |
| Nucleolus | 1 | 0 | 1 | 0 | – | 1 | 2 | 0 | 0 | 0 | 0 | 1 | 0 | 0 | 0 | 4 | 0 | 4 | 0 | 1 | 1 | 3 | 1 | 3 |
| Peroxisomes | 0 | 0 | 1 | 0 | – | 1 | 0 | 0 | 0 | 0 | 0 | 0 | 2 | 0 | 0 | 0 | 4 | 2 | 0 | 2 | 2 | 0 | 0 | 0 |
| SpindlePole | 0 | 0 | 0 | 0 | – | 0 | 0 | 5 | 9 | 3 | 5 | 5 | 2 | 0 | 0 | 7 | 13 | 18 | 3 | 15 | 10 | 23 | 33 | 63 |
| Vac/Vac Membrane | 19 | 86 | 77 | 31 | – | 24 | 43 | 37 | 42 | 26 | 41 | 24 | 81 | 51 | 37 | 104 | 117 | 96 | 25 | 62 | 71 | 89 | 78 | 105 |
| Unique Cell Count | 81 | 185 | 185 | 104 | 194 | 283 | 267 | 286 | 318 | 222 | 311 | 223 | 170 | 227 | 264 | 309 | 262 | 92 | 232 | 280 | 346 | 316 | 409 | |
| Labelled Cell Count | 111 | 212 | 223 | 117 | 254 | 388 | 343 | 385 | 416 | 308 | 421 | 251 | 192 | 244 | 343 | 386 | 345 | 92 | 232 | 280 | 346 | 316 | 409 | |
Yeast GFP Assignment
Protein Abundance
| Screen | WT1 | WT2 | WT3 | RAP60 | RAP140 | RAP220 | RAP300 | RAP380 | RAP460 | RAP540 | RAP620 | RAP700 | HU80 | HU120 | HU160 | rpd3Δ_1 | rpd3Δ_2 | rpd3Δ_3 | AF100 | AF140 | AF180 |
|---|---|---|---|---|---|---|---|---|---|---|---|---|---|---|---|---|---|---|---|---|---|
| Mean Cell GFP Intensity (1e-4) | 3.5 | 4.5 | 4.5 | 4.6 | – | 3.5 | 3.5 | 3.9 | 3.6 | 3.4 | 3.1 | 3.0 | 5.7 | 5.9 | 5.7 | 6.3 | 6.0 | 6.4 | 5.7 | 6.1 | 6.1 |
| Std Deviation (1e-4) | 0.9 | 0.9 | 1.6 | 2.5 | – | 2.0 | 2.4 | 2.2 | 1.9 | 1.8 | 1.7 | 1.0 | 1.1 | 1.3 | 1.8 | 1.6 | 1.7 | 1.9 | 1.6 | 1.8 | 2.0 |
| Intensity Change (Log2) | – | – | – | 0.05 | – | -0.34 | -0.33 | -0.19 | -0.32 | -0.42 | -0.54 | -0.59 | 0.36 | 0.4 | 0.34 | 0.5 | 0.43 | 0.53 | 0.36 | 0.44 | 0.45 |
Localization Change
| Localization | RAP60 | RAP140 | RAP220 | RAP300 | RAP380 | RAP460 | RAP540 | RAP620 | RAP700 | HU80 | HU120 | HU160 | rpd3Δ_1 | rpd3Δ_2 | rpd3Δ_3 |
|---|---|---|---|---|---|---|---|---|---|---|---|---|---|---|---|
| Actin | – | – | – | – | – | – | – | – | – | – | – | – | – | – | – |
| Bud | – | – | – | – | – | – | – | – | – | – | – | – | 0 | 0 | 0 |
| Bud Neck | – | – | – | – | – | – | – | – | – | – | – | – | 0 | 0 | 0 |
| Bud Site | – | – | – | – | – | – | – | – | – | – | – | – | 0 | 0 | 0 |
| Cell Periphery | – | – | – | – | – | – | – | – | – | – | – | – | 0 | 0 | 0 |
| Cyto | – | – | – | – | – | – | – | – | – | – | – | – | – | – | – |
| Endoplasmic Reticulum | – | – | – | – | – | – | – | – | – | – | – | – | 0 | 0 | 0 |
| Endosome | – | – | – | – | – | – | – | – | – | – | – | – | 0 | 0 | 0 |
| Golgi | – | – | – | – | – | – | – | – | – | – | – | – | 0 | 0 | 0 |
| Mitochondria | – | – | – | – | – | – | – | – | – | – | – | – | 0 | 0 | 0 |
| Nuclear Periphery | – | – | – | – | – | – | – | – | – | – | – | – | 0 | 0 | 0 |
| Nuc | – | – | – | – | – | – | – | – | – | – | – | – | – | – | – |
| Nucleolus | – | – | – | – | – | – | – | – | – | – | – | – | 0 | 0 | 0 |
| Peroxisomes | – | – | – | – | – | – | – | – | – | – | – | – | 0 | 0 | 0 |
| SpindlePole | – | – | – | – | – | – | – | – | – | – | – | – | 0 | 0 | 0 |
| Vac | – | – | – | – | – | – | – | – | – | – | – | – | – | – | – |
| Cortical Patches | – | – | – | – | – | – | – | – | – | – | – | – | 0 | 0 | 0 |
| Cytoplasm | – | – | – | – | – | – | – | – | – | – | – | – | 0 | 0 | 0 |
| Nucleus | – | – | – | – | – | – | – | – | – | – | – | – | 0 | 0 | 0 |
| Vacuole | – | – | – | – | – | – | – | – | – | – | – | – | -0.5 | -0.8 | -1.1 |
External localization resources
Images






























Protein Concentration and Protein Localization Data
| R1 | R2 | R3 | ||||||||||||||||
|---|---|---|---|---|---|---|---|---|---|---|---|---|---|---|---|---|---|---|
| G1 Pre-START | G1 Post-START | S/G2 | Metaphase | Anaphase | Telophase | G1 Pre-START | G1 Post-START | S/G2 | Metaphase | Anaphase | Telophase | G1 Pre-START | G1 Post-START | S/G2 | Metaphase | Anaphase | Telophase | |
| Concentration | – | – | – | – | – | – | – | – | – | – | – | – | – | – | – | – | – | – |
| Actin | – | – | – | – | – | – | – | – | – | – | – | – | – | – | – | – | – | – |
| Bud | – | – | – | – | – | – | – | – | – | – | – | – | – | – | – | – | – | – |
| Bud Neck | – | – | – | – | – | – | – | – | – | – | – | – | – | – | – | – | – | – |
| Bud Periphery | – | – | – | – | – | – | – | – | – | – | – | – | – | – | – | – | – | – |
| Bud Site | – | – | – | – | – | – | – | – | – | – | – | – | – | – | – | – | – | – |
| Cell Periphery | – | – | – | – | – | – | – | – | – | – | – | – | – | – | – | – | – | – |
| Cytoplasm | – | – | – | – | – | – | – | – | – | – | – | – | – | – | – | – | – | – |
| Cytoplasmic Foci | – | – | – | – | – | – | – | – | – | – | – | – | – | – | – | – | – | – |
| Eisosomes | – | – | – | – | – | – | – | – | – | – | – | – | – | – | – | – | – | – |
| Endoplasmic Reticulum | – | – | – | – | – | – | – | – | – | – | – | – | – | – | – | – | – | – |
| Endosome | – | – | – | – | – | – | – | – | – | – | – | – | – | – | – | – | – | – |
| Golgi | – | – | – | – | – | – | – | – | – | – | – | – | – | – | – | – | – | – |
| Lipid Particles | – | – | – | – | – | – | – | – | – | – | – | – | – | – | – | – | – | – |
| Mitochondria | – | – | – | – | – | – | – | – | – | – | – | – | – | – | – | – | – | – |
| None | – | – | – | – | – | – | – | – | – | – | – | – | – | – | – | – | – | – |
| Nuclear Periphery | – | – | – | – | – | – | – | – | – | – | – | – | – | – | – | – | – | – |
| Nucleolus | – | – | – | – | – | – | – | – | – | – | – | – | – | – | – | – | – | – |
| Nucleus | – | – | – | – | – | – | – | – | – | – | – | – | – | – | – | – | – | – |
| Peroxisomes | – | – | – | – | – | – | – | – | – | – | – | – | – | – | – | – | – | – |
| Punctate Nuclear | – | – | – | – | – | – | – | – | – | – | – | – | – | – | – | – | – | – |
| Vacuole | – | – | – | – | – | – | – | – | – | – | – | – | – | – | – | – | – | – |
| Vacuole Periphery | – | – | – | – | – | – | – | – | – | – | – | – | – | – | – | – | – | – |
Sequencing Data
| R1 | R2 | |||||||||
|---|---|---|---|---|---|---|---|---|---|---|
| G1 Post-START | S/G2 | Metaphase | Anaphase | Telophase | G1 Post-START | S/G2 | Metaphase | Anaphase | Telophase | |
| Gene Expression | 9.679 | 8.6524 | 5.8854 | 11.9204 | 16.2094 | 5.6429 | 11.8469 | 12.7933 | 10.6591 | 14.8371 |
| Translational Efficiency | 1.3012 | 1.0268 | 1.4493 | 0.6954 | 0.6268 | 1.5322 | 0.7395 | 0.6057 | 0.6909 | 0.6897 |
Hit Data
| Dataset | Hit |
|---|---|
| Protein Concentration | – |
| Protein Localization | – |
| Gene Expression | ✘ |
| Translational Efficiency | ✘ |
Micrographs
































Cell Count
| R1 | R2 | R1 & R2 | |||||||||
|---|---|---|---|---|---|---|---|---|---|---|---|
| WT | UBP2 | UBP14 | UBP2UBP14 | WT | UBP2 | UBP14 | UBP2UBP14 | WT | UBP2 | UBP14 | UBP2UBP14 |
| 987 | 531 | 2125 | 47 | 277 | 1261 | 1600 | 328 | 1264 | 1792 | 3725 | 375 |
Protein Abundance
| R1 | R2 | R1 & R2 | ||||||||||
|---|---|---|---|---|---|---|---|---|---|---|---|---|
| WT | UBP2 | UBP14 | UBP2UBP14 | WT | UBP2 | UBP14 | UBP2UBP14 | WT | UBP2 | UBP14 | UBP2UBP14 | |
| Mean | 613.34 | 721.09 | 776.87 | 907.48 | 643.33 | 706.12 | 782.31 | 908.83 | 619.91 | 710.56 | 779.21 | 908.66 |
| Standard Deviation | 73.24 | 106.40 | 128.97 | 157.60 | 76.47 | 104.21 | 130.25 | 198.89 | 75.00 | 105.08 | 129.55 | 194.20 |
| Intensity Change Log 2 | — | 0.233492 | 0.340986 | 0.565179 | — | 0.134354 | 0.282181 | 0.498451 | — | 0.183592 | 0.311182 | 0.531405 |
Localization Score (DeepLoc)
| R1 | R2 | R1 & R2 | ||||||||||
|---|---|---|---|---|---|---|---|---|---|---|---|---|
| WT | UBP2 | UBP14 | UBP2UBP14 | WT | UBP2 | UBP14 | UBP2UBP14 | WT | UBP2 | UBP14 | UBP2UBP14 | |
| Actin | 0.000181 | 0.000920 | 0.000643 | 0.009082 | 0.000092 | 0.001608 | 0.000602 | 0.006350 | 0.000162 | 0.001404 | 0.000625 | 0.006692 |
| Bud Neck | 0.009397 | 0.019958 | 0.037053 | 0.021258 | 0.003023 | 0.025572 | 0.020861 | 0.028064 | 0.008000 | 0.023908 | 0.030098 | 0.027211 |
| Bud Site | 0.002969 | 0.016182 | 0.019363 | 0.027055 | 0.000582 | 0.017814 | 0.030235 | 0.107103* | 0.002446 | 0.017330 | 0.024033 | 0.097070 |
| Cell Periphery | 0.000255 | 0.000255 | 0.000309 | 0.000475 | 0.000189 | 0.000615 | 0.000336 | 0.000680 | 0.000240 | 0.000508 | 0.000320 | 0.000654 |
| Cytoplasm | 0.238053* | 0.148163* | 0.058287 | 0.103490* | 0.175568* | 0.173332* | 0.168679* | 0.065175 | 0.224360* | 0.165874* | 0.105704* | 0.069977 |
| Cytoplasmic Foci | 0.075790 | 0.058127 | 0.000781 | 0.025688 | 0.042423 | 0.058894 | 0.007687 | 0.031857 | 0.068477 | 0.058667 | 0.003747 | 0.031084 |
| Eisosomes | 0.000109 | 0.000111 | 0.000028 | 0.000072 | 0.000076 | 0.000099 | 0.000061 | 0.000087 | 0.000102 | 0.000103 | 0.000042 | 0.000085 |
| Endoplasmic Reticulum | 0.001532 | 0.006510 | 0.004682 | 0.007460 | 0.001800 | 0.004715 | 0.003310 | 0.011324 | 0.001591 | 0.005247 | 0.004093 | 0.010840 |
| Endosome | 0.003611 | 0.011358 | 0.001847 | 0.029311 | 0.002116 | 0.014630 | 0.005340 | 0.062544 | 0.003284 | 0.013661 | 0.003348 | 0.058378 |
| Golgi | 0.000682 | 0.003534 | 0.000494 | 0.038860 | 0.000135 | 0.006010 | 0.001465 | 0.062858 | 0.000562 | 0.005277 | 0.000911 | 0.059850 |
| Lipid Particles | 0.009563 | 0.009356 | 0.000339 | 0.002440 | 0.006552 | 0.010211 | 0.001230 | 0.004964 | 0.008903 | 0.009957 | 0.000722 | 0.004648 |
| Mitochondria | 0.004239 | 0.012783 | 0.006373 | 0.004045 | 0.003821 | 0.022944 | 0.011245 | 0.037377 | 0.004147 | 0.019933 | 0.008466 | 0.033200 |
| Mitotic Spindle | 0.001344 | 0.005739 | 0.026935 | 0.218373* | 0.000396 | 0.032775 | 0.057294 | 0.190484* | 0.001136 | 0.024764 | 0.039975 | 0.193980* |
| None | 0.008841 | 0.008439 | 0.010773 | 0.016552 | 0.011343 | 0.006761 | 0.022923 | 0.001605 | 0.009389 | 0.007258 | 0.015992 | 0.003479 |
| Nuclear Periphery | 0.002226 | 0.003905 | 0.003323 | 0.003021 | 0.002249 | 0.005332 | 0.003025 | 0.002582 | 0.002231 | 0.004909 | 0.003195 | 0.002637 |
| Nuclear Periphery Foci | 0.000700 | 0.002074 | 0.000418 | 0.007752 | 0.000637 | 0.001550 | 0.000961 | 0.004291 | 0.000686 | 0.001705 | 0.000651 | 0.004725 |
| Nucleolus | 0.004716 | 0.009457 | 0.003566 | 0.010741 | 0.003508 | 0.008653 | 0.004496 | 0.002028 | 0.004451 | 0.008891 | 0.003966 | 0.003120 |
| Nucleus | 0.611614* | 0.635615* | 0.807622* | 0.260560* | 0.727672* | 0.543888* | 0.618954* | 0.135913* | 0.637047* | 0.571068* | 0.726583* | 0.151535* |
| Peroxisomes | 0.005793 | 0.013713 | 0.000193 | 0.001686 | 0.002104 | 0.015170 | 0.001589 | 0.005137 | 0.004985 | 0.014738 | 0.000793 | 0.004705 |
| Vacuole | 0.017922 | 0.032125 | 0.014286 | 0.127566 | 0.014418 | 0.046794 | 0.034997 | 0.194942 | 0.017154 | 0.042447 | 0.023182 | 0.186497 |
| Vacuole Periphery | 0.000464 | 0.001676 | 0.002686 | 0.084512 | 0.001296 | 0.002634 | 0.004711 | 0.044634 | 0.000646 | 0.002350 | 0.003555 | 0.049632 |
Localization Changes (T-score)
| R1 | R2 | R1 & R2 | |||||||||||||
|---|---|---|---|---|---|---|---|---|---|---|---|---|---|---|---|
| UBP2_WT | UBP14_WT | UBP2UBP14_WT | UBP2UBP14_UBP2 | UBP2UBP14_UBP14 | UBP2_WT | UBP14_WT | UBP2UBP14_WT | UBP2UBP14_UBP2 | UBP2UBP14_UBP14 | UBP2_WT | UBP14_WT | UBP2UBP14_WT | UBP2UBP14_UBP2 | UBP2UBP14_UBP14 | |
| Actin | -5.06 | -8.23 | -1.78 | -1.40 | -1.51 | -2.54 | -11.26 | -5.79 | -3.37 | -4.94 | -3.06 | -11.74 | -5.98 | -3.94 | -5.17 |
| Bud Neck | -4.09 | -14.16 | -2.81 | -0.50 | 3.02 | -11.18 | -13.70 | -9.35 | -1.04 | -1.52 | -8.96 | -16.56 | -7.78 | -1.44 | 1.71 |
| Bud Site | -3.65 | -7.75 | -4.61 | -2.06 | -2.06 | -7.86 | -9.71 | -8.89 | -6.39 | -5.83 | -7.48 | -11.29 | -8.99 | -6.65 | -6.45 |
| Cell Periphery | 0.10 | 0.28 | -0.64 | -0.68 | -0.76 | -1.35 | -2.26 | -3.69 | 0.62 | -2.68 | -1.19 | -0.44 | -2.99 | 0.47 | -2.82 |
| Cytoplasm | 7.48 | 21.82 | 6.19 | 2.76 | -0.70 | -0.08 | 2.73 | 6.39 | 10.11 | 6.45 | 6.54 | 18.06 | 14.64 | 10.16 | 1.61 |
| Cytoplasmic Foci | 2.58 | 17.82 | 8.92 | 5.87 | -2.73 | -2.68 | 7.39 | 5.04 | 11.32 | -3.75 | 2.42 | 18.79 | 13.07 | 12.79 | -5.51 |
| Eisosomes | -0.71 | 10.04 | -0.48 | -0.06 | -4.98 | -2.12 | 1.51 | -3.39 | -1.94 | -5.88 | -0.09 | 8.79 | -1.35 | -1.47 | -9.54 |
| Endoplasmic Reticulum | -9.23 | -15.94 | -3.95 | -2.78 | -2.98 | -5.48 | -8.45 | -8.72 | -6.89 | -6.16 | -11.67 | -19.17 | -10.00 | -7.21 | -6.90 |
| Endosome | -4.02 | 3.78 | -2.60 | -0.90 | -3.07 | -8.43 | -2.52 | -6.47 | -2.75 | -5.98 | -8.64 | 1.60 | -6.52 | -3.07 | -6.82 |
| Golgi | -2.59 | 1.44 | -1.36 | -1.04 | -1.40 | -4.39 | -2.53 | -4.08 | -2.85 | -3.94 | -4.63 | 0.17 | -4.20 | -3.13 | -4.21 |
| Lipid Particles | 0.21 | 11.68 | 3.57 | 3.14 | -4.02 | -2.32 | 4.40 | 1.30 | 4.77 | -4.72 | -0.83 | 12.13 | 4.50 | 5.52 | -6.21 |
| Mitochondria | -2.70 | -1.65 | 2.17 | 3.50 | 4.77 | -5.21 | -1.36 | -2.67 | 1.97 | -2.07 | -6.99 | -2.33 | -3.03 | 1.93 | -2.23 |
| Mitotic Spindle | -3.58 | -10.40 | -4.30 | -4.18 | -3.68 | -8.02 | -12.64 | -11.43 | -9.39 | -7.96 | -8.33 | -16.22 | -12.20 | -10.60 | -9.62 |
| None | 0.40 | 0.08 | 0.64 | 0.36 | 0.63 | 1.32 | -0.74 | 2.44 | 4.00 | 7.32 | 1.76 | -1.32 | 5.04 | 3.98 | 8.38 |
| Nuclear Periphery | -5.06 | -8.17 | -3.54 | -1.08 | -0.68 | -5.22 | -6.06 | -6.18 | -0.48 | -1.28 | -6.38 | -9.85 | -6.92 | -1.06 | -1.99 |
| Nuclear Periphery Foci | -4.10 | 0.29 | -2.95 | -2.72 | -2.95 | -3.05 | -2.58 | -5.54 | -4.84 | -4.79 | -5.21 | -2.20 | -6.15 | -5.37 | -5.89 |
| Nucleolus | -3.38 | -0.02 | -1.35 | -0.43 | -1.35 | -3.69 | -1.46 | -2.19 | 0.50 | -1.48 | -4.69 | -0.77 | -2.39 | 0.42 | -2.17 |
| Nucleus | -1.22 | -16.86 | 6.52 | 6.80 | 10.48 | 10.00 | 4.23 | 21.52 | 15.91 | 22.69 | 5.86 | -10.25 | 22.22 | 18.51 | 30.46 |
| Peroxisomes | -2.83 | 5.77 | 3.60 | 4.55 | -3.08 | -6.55 | 1.69 | -0.37 | 7.00 | -3.61 | -5.87 | 5.76 | 2.50 | 8.10 | -5.02 |
| Vacuole | -3.52 | 1.06 | -5.32 | -4.98 | -5.40 | -8.37 | -8.87 | -15.90 | -13.08 | -13.16 | -8.92 | -5.65 | -16.67 | -14.36 | -15.66 |
| Vacuole Periphery | -2.34 | -3.14 | -1.42 | -1.35 | -1.34 | -1.22 | -1.07 | -3.97 | -3.73 | -3.71 | -4.31 | -3.49 | -4.30 | -3.83 | -3.88 |
Endocytosis
| Temp | Actin Patch (Sac6-tdTomato) | Cortical Patch (Sla1-GFP) | Late Endosome (Snf7-GFP) | Vacuole (Vph1-GFP) |
|---|---|---|---|---|
| 37℃ | ||||
| RT |
Cell Cycle Omics
CYCLoPs (Cdc40-GFP)
| Gene / Allele | Actin Patch (Sac6-tdTomato) | Cortical Patch (Sla1-GFP) | Late Endosome (Snf7-GFP) | Vacuole (Sac6-tdTomato) |
|---|
| Gene | Images |
|---|
| Gene | Images |
|---|
Images are not yet available
Images are not yet available